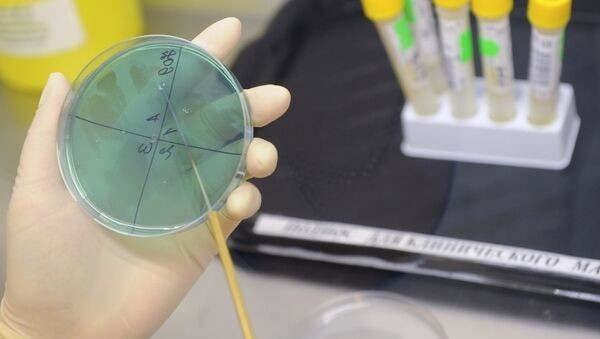

One of people infected with anthrax dies in Kazakhstan

AKIPRESS.COM - One of the residents of Topar village in Karaganda region of Kazakhstan who got infected with anthrax has died, the regional health department reported...
AKIPRESS.COM - One of the residents of Topar village in Karaganda region of Kazakhstan who got infected with anthrax has died, the regional health department reported...
All rights reserved
© AKIpress News Agency - 2001-2026.
Republication of any material is prohibited without a written agreement with AKIpress News Agency.
Any citation must be accompanied by a hyperlink to akipress.com.
Our address:
299/5 Chingiz Aitmatov Prosp., Bishkek, the Kyrgyz Republic
e-mail: english@akipress.org, akipressenglish@gmail.com;